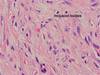

Dermatopathology #3 Flashcards
(153 cards)
What’s the diagnosis? Note the follicular induction and collagen trapping at the periphery.

Dermatofibroma
What’s the diagnosis?

Dermatofibroma
In which condition do “collagen balls” often form?

Dermatofibromas

Will dermatofibromas be positive or negative for CD34? What about factor XIIIa?
Classically dermatofibromas will be CD34- and factor XIIIa+
*Note: these stains can help to distinguish them from DFSP.
In which conditions is factor XIIIa typically positive? List four conditions.
- Dermatofibromas
- Fibrous papules of the face
- Angiofibromas
- Acquired digital fibrokeratomas
What’s the diagnosis? Hint: this is a type of dermatofibroma.

Aneurysmal dermatofibroma

What’s the diagnosis? Hint: this is a type of dermatofibroma.

Fibrous histiocytoma
What condition are hemosiderin-laden Touton giant cells (rigned siderophages) pathognomonic for?

Dermatofibroma
True or false: “dermatofibroma with monster cells” is considered a type of dermatofibroma.

True
*Note: the “monster cells” comprise cells with large hyperchromatic atypical nuclei.

What’s the diagnosis? Note the pale blue nodules embedded in a more cellular background. Hint: this is composed of myofibroblasts.

Adult myofibroma
*Note: the pale blue myofibroblasts have a colour very similar to cartilage.

What’s the diagnosis?

Adult myofibroma
What’s the diagnosis? Note the spindle cells with an East-West orientation and the corkscrew appearance of some myofibroblasts.

Dermatomyofibroma

What’s the most likely diagnosis in this biopsy from a plaque-like tumor showing a proliferation of spindle cells and cells with corkscrew nuclei. Hint: at scanning magnification, the sparing of adnexal structures is more obvious.

Dermatomyofibroma
Could the diagnosis be dermatomyofibroma?

Yes; dermatomyofibromas typically contain very thick elastic fibers
True or false: corkscrew nuclei are typical of myofibroblastic proliferations.

True; this is a biopsy of a Dupuytren’s contracture
What’s the most likely diagnosis in this biopsy taken from the plantar fascia? Note the nodules of myofibroblasts.

Lederhose disease (basically Dupuytren’s contractures of the plantar fascia)

True or false: these corkscrew nuclei could come from Lederhose disease.

True
*Note: Lederhose disease is basically Dupuytren’s contractures of the plantar fascia.
True or false: this biopsy could represent infantile myofibromatosis.

True; all forms of myofibromatosis have a tendency to form thick “ropy” collagen bundles, and the myofibroblasts often run in fascicles
What’s the diagnosis?

Scar
What’s the diagnosis in this previously traumatized area?

Hypertrophic scar
The term “acrospiroma” encompasses a large family of sweat gland tumors. Name the four major diagnoses within this category.
- Poromas
- Hidradenomas
- Dermal duct tumors
- Hidroacanthoma simplex
*Note: acrospiromas have a tendency towards clear cell change. Cuticle-lined ducts are usually present.
What’s the diagnosis in this previously traumatized area?

Keloid

True or false: this could be consistent with an infantile digital fibroma.

True
*Note: there are characteristic inclusion bodies adjacent to the nuclei.
**Note: this have high recurrance rates after excision, although they are benign.
What’s the most likely diagnosis in this biopsy showing plump fibroblasts and osteoclast-like giant cells?

Giant cell tumor of the tendon sheath




















































































































































































